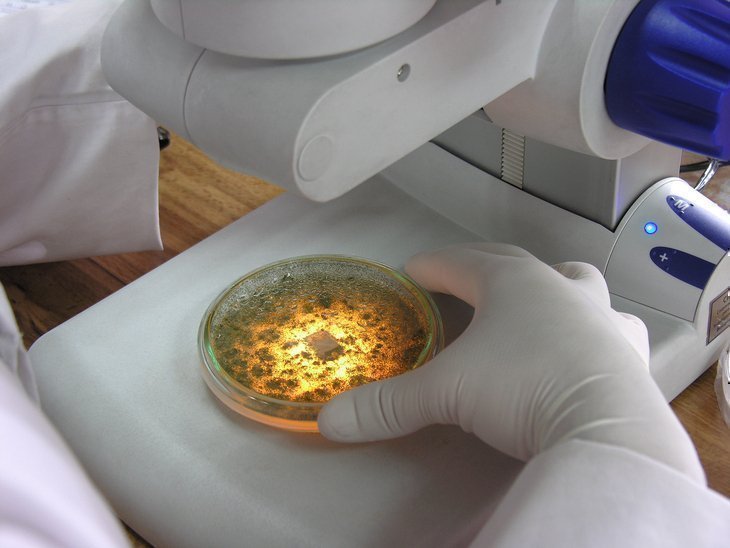
Cortesía: Corporación para Investigaciones Biológicas

La CIB, primeros 50 años de investigación para la salud pública en Colombia
Agencia de Noticias UPB – Medellín. La Corporación para Investigaciones Biológicas (CIB) es un centro de investigación científico orientado a la producción y divulgación de nuevo conocimiento, fundado en 1970. Hoy, luego de 50 años, siguen aportando a la salud pública, la biodiversidad y la biotecnología agrícola y ambiental en Colombia.
Actualmente cuenta con dos ejes de investigación: BAYA, que se enfoca en los entornos agrícolas de Colombia y CIB Salud, que es una IPS especializada en el manejo de pacientes ambulatorios con enfermedades.
Cada eje investigativo cuenta con grupos especializados de investigación que están enlazados con varias universidades del país como socios estratégicos, siendo, algunos de ellos, la Universidad de Antioquia, la Universidad Nacional de Colombia, el Colegio Mayor, la Universidad de Santander y la Universidad Pontificia Bolivariana.
Alianza entre la UPB y la CIB
Mónica Uribe, docente investigadora de la Facultad de Medicina de la UPB, explicó que esta alianza significa “un aprendizaje y crecimiento continuo. Hemos sido aliados, permitiéndonos crecer como instituciones desde lo investigativo y lo académico.” Además, agregó que “como sociedad y ciudad debemos apoyarlas porque son instituciones que generan riqueza de conocimiento, una riqueza que es muy importante para solucionar problemas como lo está demostrando esta pandemia: instituciones como la CIB van a ser las encargadas de ayudar a prevenir enfermedades futuras”.
La formación académica, de la mano con la investigación, siempre han sido clave para el desarrollo de las sociedades. De esta manera, la alianza entre la UPB y la CIB tiene un peso significativo, tanto para cada entidad, como para el equilibrio de la sociedad. Por eso, desde esta alianza se trabajan proyectos de investigación en pro del bienestar colectivo.

Jaime Cano, director de la CIB, comentó que la relación de estas dos instituciones es simbiótica, donde hay un flujo de conocimiento, formación, capacitación y transferencia constante.
La CIB, en alianza con la UPB, tiene dos grupos de investigación en el área de la salud: Micología Médica y Experimental, y Micobacterias y Tuberculosis, ambos certificados como grupos de categoría A1 por Colciencias. Estos grupos están conformados por estudiantes de pregrado, posgrado y docentes de la Escuela de la Salud de la UPB.
Conoce más sobre la Unidad de Bacteriología y Micobacterias, CIB-UPB
Tonny Naranjo, delegado del grupo de Micología Médica y Experimental desde la Universidad, comentó que este grupo tiene mucho significado, tanto para la Escuela de Ciencias de la Salud de la UPB como para la CIB, porque fue a raíz de él que surgió el Centro de Investigación Biológica, con la dirección de la doctora Ángela Restrepo, una de las fundadoras de esta institución.
Actualmente, el proyecto bandera que se está realizando conjuntamente es el Programa NanoBioCáncer, de Colombia Científica. Cuando salió la convocatoria de Colombia Científica, entre la CIB y la UPB investigaron las categorías a las que se les estaban dando prioridad y una de ellas era enfermedades crónicas.

Este programa, liderado por la UPB, se denomina “Alianza académico-científica para el fortalecimiento de las IES, enfocada en la nanobioingeniería para la prevención, el diagnóstico y el tratamiento del cáncer de colon”, que busca diseñar y crear dispositivos a escala nano para la detección temprana de este cáncer.
NanoBioCáncer fue el único programa en salud que se aprobó desde Colombia Científica, resaltando el proceso de investigación entre la UPB y la CIB por encima de universidades con facultades muy reconocidas en el país que también participaron en esta convocatoria.
Este proyecto muestra una de las grandes fortalezas de esta alianza: la posibilidad de poder proyectarse con más peso en las convocatorias que se presenten. “Tenemos esa facilidad de optar por los dos lados. No importa el tipo de convocatoria o qué entidad participe, tanto la CIB como la UPB saldrán beneficiadas porque somos el mismo grupo”, agregó Tonny.
Conoce más sobre el Programa NanoBioCáncer de la UPB
La CIB cumple 50 años
Esta institución cuenta con un largo recorrido transmitiendo conocimiento de alto valor científico y académico e investigación sostenible. Jaime Cano comentó que este acontecimiento es un momento importante para reevaluar sus capacidades.

“Creo que estos 50 años nos han demostrado que tenemos 4 premisas fundamentales que cumplir para los próximos años en este proceso de crecer y son: ser socialmente aceptables, económicamente rentables, ambientalmente sostenibles y culturalmente integradores”, expuso el director.
Además, Jaime Cano agregó que toda esta experiencia refleja que la CIB va más allá de ser una corporación, y se convierte en “un espacio donde mucha gente ve reflejada su profesionalidad con un impacto social muy grande. Nosotros damos muchas gracias por permitirnos en la vida cumplir 50 años y miramos hacia atrás con mucho respeto frente a los demás que han estado liderando y trabajando en esta Corporación”.
Por Laura Gómez Londoño. Agencia de Noticias UPB.